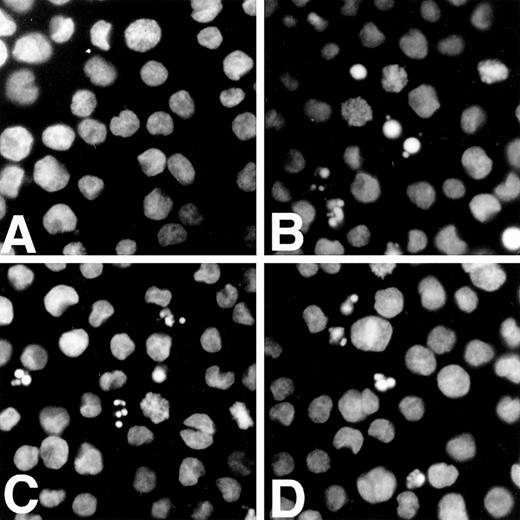
Fig. 4. Trivalent antimonials induce apoptosis of APL cells. Untreated NB4 cells (A) or cells treated for 24 hours with either 1 μmol/L As2O3 (B), 1 μmol/L Sb2O3 (C), or 1 μmol/L PAT (D) were bound to poly-Lysine treated coverslips, fixed and stained with Hoechst 33258. Apoptotic cells show chromatin condensation and micronuclei.

Abstract
Acute promyelocytic leukemia (APL) is characterized by a specific t(15;17) chromosomal translocation that fuses the genes encoding the promyelocytic leukemia protein (PML) and the retinoic acid receptor (RAR). The resulting PML-RAR protein induces a block in the differentiation of the myeloid progenitor cells, which can be released by retinoic acid (RA) in vitro and in vivo. The RA-induced differentiation of APL blasts is paralleled by the degradation of the fusion protein and the relocation of wild-type PML from aberrant nuclear structures to its normal localization in nuclear bodies. Recently, arsenic trioxide (As2O3) treatment was proposed as an alternative therapy in APL, because it can induce complete remission in both RA-sensitive and -resistant APL patients. Intriguingly, As2O3 was also shown to induce degradation of the PML-RAR chimera and to reorganize PML nuclear bodies. Here we show that trivalent antimonials also have striking effects on RA-sensitive and RA-resistant APL cells. Treatment of the APL-derived NB4 cells and the RA-resistant subclone NB4R4 with antimony trioxide or potassium antimonyl tartrat triggers the degradation of the fusion protein and the concomitant reorganization of the PML nuclear bodies. In addition, as reported for As2O3, the antimonials provoke apoptosis of NB4 and NB4R4 cells. The mechanism of antimony action is likely to be similar to that of As2O3, notably both substances induce the attachment of the ubiquitin-like SUMO-1 molecule to the PML moiety of PML-RAR. From these data, we propose that, in analogy to As2O3, antimonials might have a beneficial therapeutic effect on APL patients, perhaps with less toxicity than arsenic.
ACUTE PROMYELOCYTIC leukemia (APL) represents about 10% of acute myeloid leukemia cases. APL is characterized by a specific differentiation block of the myeloid progenitor cells at the promyelocytic stage. At the molecular level, in the vast majority of cases (>95%), APL blasts harbor the balanced t(15;17) chromosomal translocation, which fuses the promyelocytic leukemia protein (PML) gene located on chromosome 15 to the retinoic acid receptor α (RARα) gene on chromosome 17.1-5 The PML-RARα fusion protein retains most of the functional domains of the parental PML and RARα proteins. The key role of the chimera in the differentiation block has initially been shown in in vitro models,6,7 and its oncogenic potential has more recently been confirmed in transgenic mice.8-11 A unique feature of APL blasts is their ability to undergo terminal differentiation after retinoic acid (RA) treatment in vitro as well as in vivo.12-14 Indeed, oral administration ofall-transRA, the natural ligand for RARα, induces complete remission in t(15;17) APL patients, making APL the first example of differentiation therapy in treatment of advanced cancer. Several clinical studies have conclusively shown that the combination of RA with chemotherapy has improved the survival of patients with APL.15-17
The PML-RARα chimera may exert its dominant negative effect on myelocyte differentiation by interfering with both RARα or PML signaling pathways. Whereas the role of retinoids and their receptors in cellular differentiation processes have at least been partially elucidated, the biological function of PML is still poorly understood. An important observation was the detection of its altered subcellular localization in APL cells. In normal cells, PML has been shown to localize to distinct subnuclear domains, the so-called PML nuclear bodies (NBs), ND 10 or PODs,18-20 that are tightly associated with the nuclear matrix. Whereas normal cells contain 10 to 30 NBs per nucleus, in APL cells, NBs are highly disorganized into numerous and aberrant microstructures containing both PML and PML-RARα. Strikingly, RA treatment induces a drastic reorganization of the NBs back to their normal number and morphology, suggesting that the delocalization of PML or other NB-associated proteins may play a role in APL pathogenesis. More recent data have shown that RA-induced restoration of PML bodies is paralleled by a selective degradation of the PML-RARα fusion protein,21 22 suggesting that NB restoration is a direct consequence of PML-RARα disappearance.
Despite the broad success of RA therapy in APL, a significant percentage (20% to 30%) of patients relapse after initial remission and subsequently develop resistance to RA treatment. The clinical outcome of these patients is poor, as an effective substitute for RA is not yet available. Recently, arsenic trioxide (As2O3), a component of antileukemic drugs used in Chinese traditional medicine, was proposed as an alternative therapy in the treatment of APL.23-25 In vitro studies performed in freshly isolated APL blasts and in the APL-derived NB4 cell line showed that As2O3 exerts a dose-dependent dual effect on APL cells. At concentrations of 1 μmol/L and above, it induced preferentially apoptotic cell death, whereas at lower concentrations partial differentiation of APL cells was observed.23,24However, when given in vitro in combination with RA, As2O3 inhibited differentiation, and RA inhibited As2O3-induced apoptosis in APL cell lines and patient samples.26 Most intriguingly, similarly to RA, As2O3 drastically changed the metabolic stability of the fusion protein, triggering PML-RARα degradation within 6 to 8 hours, and provoked the restoration of enlarged PML NBs.24,26-28 Recently, we and others have shown that both PML and PML-RARα are posttranslationally modified by covalent linkage with the ubiquitin-like SUMO-1 protein,28-30 formerly named PIC-1.31 The unmodified form of PML is found in the soluble nucleoplasmic fraction, whereas the SUMO-1 modified forms are compartmentalized exclusively in the PML NBs, indicating that covalent modification of PML with SUMO-1 is implicated in its targeting to these structures.28 Strikingly, As2O3treatment alters the profile of SUMO-1 modification by inducing the attachment of multiple SUMO-1 molecules to both PML and PML-RARα. Whereas the poly–SUMO-1–modified forms of wild-type PML are metabolically stable and concentrate in NBs, poly–SUMO-1 modification of PML-RARα is accompanied by a decrease in the metabolic stability of the fusion protein by a yet unknown mechanism.
It has been shown that trivalent antimonials can interfere in a number of biological processes in a similar manner to trivalent arsenics, a phenomenon that has been explained by the chemical similarity of both substances.32,33 Arsenic and antimony are elements from group V of the periodic table, classified as metalloids. The potential of their trivalent salts to interact with biochemical reactions has been ascribed in particular to their ability to target vicinal thiol groups in proteins with quite a high specificity.34 In this study we report that trivalent antimonials, such as antimony trioxide (Sb2O3) and potassium antimonyl tartrat (PAT), can perfectly mimic the effects of As2O3 on APL cells. Like arsenic, the antimonials are effective in triggering PML-RARα degradation, NB reorganization, and conjugation with the SUMO-1 modifier. In addition, they preferentially provoke apoptosis of APL cells. Based on these observations we suggest that, in analogy to As2O3, antimonials might have a beneficial effect in the treatment of APL patients.
MATERIALS AND METHODS
Cell culture and treatment of cells.
NB4 cells,35 NB4R4,36 and U937 cells were cultured in RPMI medium (GIBCO-BRL, Gaithersburg, MD) supplemented with antibiotics, glutamine, and 10% fetal calf serum. The HeLa cell line stably overexpressing PML(F) was as previously described.28 The cells were grown at 37°C in 5% CO2 in Dulbecco’s modified minimal essential medium (GIBCO-BRL), supplemented with antibiotics, glutamine, 10% fetal calf serum and with G418 (Geneticin, GIBCO-BRL; 750 μg/mL).All-trans RA (Sigma Chemical Company, St Louis, MO) was prepared as a 10 mmol/L stock solution in ethanol; As2O3(Sigma) as a 1 mmol/L stock solution in PBS; PAT (Aldrich), and meglumine antimonate (Glucantime; Rhône-Poulenc, Paris, France) as 10 mmol/L stock solutions in H2O. Sb2O3 (Fluka, Buchs, Switzerland) and Bi2O3 (Sigma) were dissolved in a minimal volume of HCl and a 100 μmol/L stock solution prepared in 100 mmol/L HEPES, pH 7.5.
Antibodies.
The polyclonal anti-PML antibody and the monoclonal anti–SUMO-1 antibody (21C7) were as described previously.19,37 The anti-human RARα rabbit polyclonal antibody (RPαF-115)38and the anti-F antibody Ab(F3)39 ascites fluid and hybridoma culture supernatant were provided by M.-P. Gaub, D. Metzger, and P. Chambon (IGBMC, Illkirch, France).
Preparation of cell extracts and Western blotting.
For Western blots, approximately 5 × 106 cells were washed twice in phosphate-buffered saline (PBS), lysed in 250 μL sodium dodecyl sulfate (SDS)-sample buffer, and boiled for 10 minutes. Proteins were separated by 7.5% sodium dodecyl sulfate-polyacrylamide gel electrophoresis (SDS-PAGE) and transferred to Hybond-C extra (Amersham, Arlington Heights, IL) membranes. Membranes were blocked in 5% nonfat dry milk in phosphate-buffered saline–0.05% Tween (PBST) and incubated for 2 hours with the various antibodies diluted in PBST. The anti-PML antibody was used at a dilution of 1:2,500, the anti-F Ab(F3) hybridoma cell culture supernatant at 1:200, and anti-RARα (RPαF-115) at 1:500. After primary antibody incubation, blots were extensively washed in PBST and incubated for 1 hour with the appropriate peroxidase coupled secondary antibodies (Amersham). Enhanced chemiluminescence reagents (ECL; Amersham) were used for detection.
Indirect immunofluorescence and confocal laser microscopy.
NB4 or NB4R4 cells were washed twice in PBS, 1 × 106cells were resuspended in 100 μL PBS, and attached on poly-Lysine (Sigma) treated coverslips. Cells were fixed in 3.7% paraformaldehyde (PFA) in PBS for 10 minutes at room temperature and then permeabilized with 0.5% Triton X-100 in PBS for 20 minutes at room temperature. After fixation and permeabilization, cells were rinsed twice in PBS and once in PBST, incubated with primary antibodies for 1 hour, washed in PBS and PBST, and further incubated with the appropriate secondary antibodies conjugated with either fluorescein (Sigma) or Texas red (Amersham). Primary antibodies were used at a dilution of 1:200 for anti-PML and 1:500 for anti–SUMO-1, and secondary antibodies were used at a dilution of 1:200. After three washes in PBS, the samples were mounted in VectaShield (Vector Laboratories, Burlington, CA). Confocal laser scanning microscopy was performed with an LEICA SM microscope (Heidelberg, Germany) using excitation wavelengths of 488 nm (for fluorescein) and 543 nm (for Texas red). The two channels were recorded independently and pseudocolour images were generated and superimposed. The acquired digital images were processed using Adobe Photoshop v.3.1 software (San Jose, CA).
Apoptosis assays.
Five-milliliter cultures of NB4, NB4R4, or U937 cells at a density of 2 × 105 cells/mL were incubated with 1 μmol/L As2O3, 1 μmol/L Sb2O3, or 1 μmol/L PAT. Aliquots of the cells were removed after 24 hours and 48 hours, and the cells were bound to poly-Lysine (Sigma) treated coverslips. Cells were fixed with 3.7% PFA in PBS for 10 minutes at room temperature and then stained for 5 minutes with PBS containing 1 μg/mL Hoechst 33258 (Sigma). After rinsing with PBS, morphological assessment of cells was made by epifluorescence microscopy.
RESULTS
Trivalent antimonials trigger the degradation of PML-RARα in RA-sensitive and -resistant APL cells.
The potential to induce degradation of the PML-RARα fusion protein seems to be critical for the antileukemogenic activity of both RA and As2O3. As antimonials share several chemical properties with arsenics, we were tempted to determine the effect of antimony trioxide (Sb2O3) on the PML-RARα level in the APL-derived NB4 cells. To this aim, cellular extracts were prepared from untreated NB4 cells and from cells treated with either 1 μmol/L As2O3 or 1 μmol/L Sb2O3 for 12 hours. For direct comparison, an extract from NB4 cells treated for 36 hours with 1 μmol/L RA was included in the experiment. An extract from cells treated with 1 μmol/L bismuth trioxide (Bi2O3), another trivalent metalloid from group V of the periodic table, served as a control to determine whether group V metals in general can act on PML-RARα. Proteins from the extracts were separated by SDS-PAGE and the PML-RARα protein levels in the samples were measured by immunoblotting with an anti-RARα antibody (Fig1, lanes 1 through 5). The wild-type RARα receptor, migrating as a doublet-band at approximately 50 kD, was detected in equal amounts in all extracts. In extracts from untreated cells (lane 1), a major PML-RARα band migrating at 120 kD together with two higher anti-RARα reactive bands at 140 kD and 160 kD, were visible. We have recently shown that these higher molecular weight species correspond to PML-RARα forms where one or two molecules of the ubiquitin-like SUMO-1 protein are covalently linked to the PML moiety of the fusion protein.28 As expected, incubation of the cells with either RA or As2O3 leads to a complete disappearance of all of these PML-RARα bands (lanes 2 and 3). The novel anti-RARα reactive band migrating at 80 kD observed after RA treatment (lane 2) represents a PML-RARα cleavage product described previously.19,21 27 Interestingly, treatment of cells with 1 μmol/L Sb2O3 also induces an almost complete degradation of PML-RARα (lane 4). In contrast, Bi2O3 treatment had no effect on the level of the PML-RARα protein (lane 5), underlining the specificity of As2O3 and Sb2O3. In addition to Sb2O3, we tested two other antimony compounds, the PAT and the pentavalent antimonial meglumine antimonate, for their potential to induce PML-RARα downregulation in NB4 cells. Whereas PAT was as effective as Sb2O3 in triggering degradation of the fusion protein, the pentavalent antimony salt had no effect on PML-RARα levels (data not shown).
Trivalent antimonials trigger the degradation of PML-RAR in RA-sensitive and -resistant APL cells. Cellular extracts from NB4 cells (lanes 1 through 5) and from the RA-resistant NB4R4 cells (lanes 6 through 10) were prepared in SDS sample buffer. Cells were untreated (lanes 1 and 6), treated with either 1 μmol/L RA for 36 hours (lanes 2 and 7) or 1 μmol/L As2O3(lane 3 and 8), or 1 μmol/L Sb2O3 (lanes 4 and 9) or 1 μmol/L Bi2O3 (lanes 5 and 10) for 12 hours. Proteins were separated on a 7.5% SDS-PAGE gel, transferred to a nitrocellulose membrane, and probed with an anti-RAR polyclonal antibody. The 120-kD PML-RAR and the 50-kD RAR proteins are indicated by arrowheads. The SUMO-1–PML-RAR conjugates are indicated by open triangles and the 80-kD PML-RAR cleavage product observed after RA treatment is indicated by an asteriks.
Trivalent antimonials trigger the degradation of PML-RAR in RA-sensitive and -resistant APL cells. Cellular extracts from NB4 cells (lanes 1 through 5) and from the RA-resistant NB4R4 cells (lanes 6 through 10) were prepared in SDS sample buffer. Cells were untreated (lanes 1 and 6), treated with either 1 μmol/L RA for 36 hours (lanes 2 and 7) or 1 μmol/L As2O3(lane 3 and 8), or 1 μmol/L Sb2O3 (lanes 4 and 9) or 1 μmol/L Bi2O3 (lanes 5 and 10) for 12 hours. Proteins were separated on a 7.5% SDS-PAGE gel, transferred to a nitrocellulose membrane, and probed with an anti-RAR polyclonal antibody. The 120-kD PML-RAR and the 50-kD RAR proteins are indicated by arrowheads. The SUMO-1–PML-RAR conjugates are indicated by open triangles and the 80-kD PML-RAR cleavage product observed after RA treatment is indicated by an asteriks.
To see whether Sb2O3 can similarly induce PML-RARα degradation in RA-resistant APL cells, we used the RA-resistant NB4R4 cell line as a model system. In this cell line, the PML-RARα chimera harbors a point mutation in the ligand-binding domain of the RARα moiety, preventing ligand binding and RA-induced differentiation.36,40 NB4R4 cells were cultured as described above in the presence of the different chemicals, and their respective effect on PML-RARα levels was determined by Western blotting (Fig 1, lanes 6 through 10). In untreated cells, PML-RARα is seen as the typical triplet of bands corresponding to both unmodified and SUMO-1–modified chimera species (lane 6). As reported before,21 RA is not able to trigger PML-RARα degradation in these cells (lane 7). In contrast, both As2O3 (lane 8) and Sb2O3 (lane 9) treatment, but not incubation with Bi2O3 (lane 10), drastically reduce the amount of PML-RARα to hardly detectable levels.
Taken together these data show that similarly to RA and As2O3, trivalent antimonials induce a targeted degradation of the PML-RARα oncoprotein. Like arsenic, the potential of antimonials to degrade PML-RARα is not abrogated in an RA-resistant APL cell line, indicating that both compounds act by a mechanism that is distinct from that of retinoids.
Trivalent antimonials induce poly–SUMO-1 modification of wild-type PML.
We have recently shown that As2O3 targets the PML moiety of PML-RARα by inducing the attachment of multiple SUMO-1 molecules to PML.28 This posttranslational modification is most easily detected on Western blots from PML-overexpressing cells, as the As2O3-induced formation of poly–SUMO-1–PML conjugates leads to a dramatic change in the electrophoretic mobility of these PML forms in SDS-PAGE. To examine whether antimonials have any effect on SUMO-1 modification of PML, we incubated cells from a HeLa cell line overexpressing PML, tagged with the F region of the human estrogen receptor, with either 1 μmol/L Sb2O3, PAT, or meglumine antimonate for 6 hours. Extracts from untreated cells and from cells treated with RA or Bi2O3 were used as controls. The PML and the PML–SUMO-1 conjugates were detected by immunoblotting with a monoclonal antibody directed against the F tag (Fig2). In untreated cells (lane 1) as well as in RA-treated cells (lane 2), the antibody detects a major PML(F) form showing an apparent molecular mass of 100 kD. In addition, four higher molecular weight PML species are seen migrating between 20 and 60 kD above this major form. These bands correspond to SUMO-1–PML conjugates, where one or more SUMO-1 molecules are covalently attached to PML. As reported previously, As2O3 induces the conversion of these oligo–SUMO-1–modified PML forms toward poly–SUMO-1–modified species, migrating from 160 kD toward the top of the gel (lane 3). Strikingly, the same phenomenon was observed in cellular extracts from cells that had been treated with either Sb2O3 (lane 4) or PAT (lane 5). In contrast, incubation of cells with either the pentavalent meglumine antimonate (lane 6) or Bi2O3 (lane 7) did not alter the profile of SUMO-1–modified PML forms.
Trivalent antimonials induce poly–SUMO-1 modification of wild-type PML. Cellular extracts from HeLa cells stably overexpressing PML(F) were prepared in SDS sample buffer. Cells were either untreated (lane 1) or treated with 1 μmol/L RA (lane 2), 1 μmol/L As2O3 (lane 3), 1 μmol/L Sb2O3 (lane 4), 1 μmol/L PAT (lane 5), 1 μmol/L meglumine antimonate (lane 6), or 1 μmol/L Bi2O3 (lane 7). Proteins were run on a 7.5% SDS-PAGE gel, transferred to a nitrocellulose membrane, and the blot was immunostained with a monoclonal antibody directed against the F tag. The unmodified 100-kD PML form is indicated by an open triangle. The oligo–SUMO-1–modified PML forms migrating between 120 and 160 kD are indicated by arrowheads and the high molecular poly–SUMO-1–modified PML species forming a smear toward the top of the gel by a square bracket. The ∼68-kD band represents a protein cross-reacting with the anti-F antibody that has been described previously.39
Trivalent antimonials induce poly–SUMO-1 modification of wild-type PML. Cellular extracts from HeLa cells stably overexpressing PML(F) were prepared in SDS sample buffer. Cells were either untreated (lane 1) or treated with 1 μmol/L RA (lane 2), 1 μmol/L As2O3 (lane 3), 1 μmol/L Sb2O3 (lane 4), 1 μmol/L PAT (lane 5), 1 μmol/L meglumine antimonate (lane 6), or 1 μmol/L Bi2O3 (lane 7). Proteins were run on a 7.5% SDS-PAGE gel, transferred to a nitrocellulose membrane, and the blot was immunostained with a monoclonal antibody directed against the F tag. The unmodified 100-kD PML form is indicated by an open triangle. The oligo–SUMO-1–modified PML forms migrating between 120 and 160 kD are indicated by arrowheads and the high molecular poly–SUMO-1–modified PML species forming a smear toward the top of the gel by a square bracket. The ∼68-kD band represents a protein cross-reacting with the anti-F antibody that has been described previously.39
In summary, these result indicate that, like As2O3, trivalent antimonials act specifically on the PML moiety of the PML-RARα fusion protein by inducing the formation of poly–SUMO-1– modified PML conjugates.
Trivalent antimonials trigger the reorganization of the PML NBs in APL cells.
The observation that both RA and As2O3 are able to redirect wild-type PML from its aberrant subnuclear distribution in APL cells to its normal localization led us to examine PML localization after treatment with antimony. With regard to the apparent role of the modification by SUMO-1 in targeting PML to the NBs, the intracellular distribution of SUMO-1 was determined in parallel. Indirect immunofluorescence microscopy was done on untreated NB4 cells, as well as on cells treated for 36 hours with RA or for 10 hours with either As2O3, Sb2O3, Bi2O3, PAT, or meglumine antimonate. Double labeling was performed with a polyclonal anti-PML antibody and an anti–SUMO-1 monoclonal antibody, and the localization of both proteins was analyzed by confocal laser microscopy (Fig 3 and data not shown). In untreated NB4 cells, PML shows the microspeckled appearance typical for APL cells (Fig 3A). SUMO-1 staining reveals an intense nuclear diffuse signal and, in addition, some concentration in nuclear punctate structures (Fig 3B). Superposition of PML and SUMO-1 stainings shows the colocalization of both proteins in the APL-specific microspeckles, which can be seen more easily in the largest of these structures (Fig3C). After RA treatment, PML is predominantly found in the restored PML NBs, although a nonnegligible fraction remains diffusely distributed in the nucleoplasm (Fig 3D). SUMO-1 undergoes a similar relocalization process and, in addition to its nuclear diffuse localization, the protein can now be clearly detected in distinct subnuclear aggregates (Fig 3E), where it colocalizes with PML (Fig 3F). Incubation of NB4 cells with As2O3 induces a characteristic redistribution of PML (Fig 3G) together with SUMO-1 (Fig 3H) from the microspeckled structures to intact NBs, where both proteins colocalize (Fig 3I). However, in contrast to RA, As2O3also induces the concentration of the nuclear diffuse PML and SUMO-1 fractions into the NBs, which, in consequence, are significantly larger than the bodies reformed in RA-treated cells. Treatment of NB4 cells with Sb2O3 similarly leads to a drastic reorganization of the immunofluorescence patterns. Both PML and SUMO-1 are corecruited onto dramatically enlarged NBs, whereas the nuclear diffuse SUMO-1 staining is greatly diminished (Fig 3, J through L). Treatment of cells with Bi2O3 had no effect on PML or SUMO-1 localization, when compared with untreated controls (Fig 3, compare M through O with A through C). Among the two other antimonials tested, the trivalent PAT was as effective as Sb2O3 in triggering NB reorganization, whereas meglumine antimonate could neither alter PML nor SUMO-1 localization (data not shown). In the RA-resistant NB4 subclone NB4R4, arsenic and the trivalent antimonials, but not RA, provoked the reorganization of the NBs accompanied by recruitment of SUMO-1 onto these structures (data not shown). After exposure of both NB4 and NB4R4 cells for 24 to 36 hours to arsenic or 48 hours to antimonials, the immunofluorescence staining of PML and SUMO-1 became more diffuse and the NBs were hardly detectable. In cells that show morphological signs of apoptosis such as micronucleation and chromosome condensation (see below), a complete loss of PML and SUMO-1 staining was seen (not shown).
Trivalent antimonials trigger the reorganization of PML NBs in APL Cells. NB4 cells were subjected to double-immunofluorescence staining with a polyclonal anti-PML antibody and a monoclonal anti–SUMO-1 antibody. Labeling was performed on untreated cells (A through C), cells treated for 36 hours with 1 μmol/L RA (D through F), or cells treated for 10 hours with either 1 μmol/L As2O3 (G through I), 1 μmol/L Sb2O3 (J through L), or 1 μmol/L Bi2O3 (M through O). The staining pattern was analyzed by confocal laser microscopy. The red signal (PML) is obtained with an anti-rabbit Ig Texas red–conjugated secondary antibody, the green signal (SUMO-1) with an anti-mouse Ig fluorescein–conjugated secondary antibody. Superimposing of the two colors (merge) results in a yellow signal, where both proteins colocalize.
Trivalent antimonials trigger the reorganization of PML NBs in APL Cells. NB4 cells were subjected to double-immunofluorescence staining with a polyclonal anti-PML antibody and a monoclonal anti–SUMO-1 antibody. Labeling was performed on untreated cells (A through C), cells treated for 36 hours with 1 μmol/L RA (D through F), or cells treated for 10 hours with either 1 μmol/L As2O3 (G through I), 1 μmol/L Sb2O3 (J through L), or 1 μmol/L Bi2O3 (M through O). The staining pattern was analyzed by confocal laser microscopy. The red signal (PML) is obtained with an anti-rabbit Ig Texas red–conjugated secondary antibody, the green signal (SUMO-1) with an anti-mouse Ig fluorescein–conjugated secondary antibody. Superimposing of the two colors (merge) results in a yellow signal, where both proteins colocalize.
The data from immunofluorescence show that trivalent antimonials can efficiently trigger PML NB reorganization. In contrast to the NB restoration provoked by RA, the arsenic/antimony-induced reorganization of NBs is also accompanied by an important swelling of the structures, followed by a loss of PML staining.
Trivalent antimonials induce apoptosis of retinoid-sensitive and -resistant APL cells.
It has been suggested that the therapeutic effect of As2O3 might, at least partially, be due to its potential to induce apoptosis in APL cells.23-26 To determine whether antimonials have an apoptotic effect on APL cells, NB4 and NB4R4 cells were cultured in the presence of 1 μmol/L As2O3, 1 μmol/L Sb2O3, or 1 μmol/L PAT. After 24 hours and 48 hours, cells were stained with the DNA colorant Hoechst 33258 to detect apoptotic nuclei. Hoechst-stained NB4 cells after incubation for 24 hours with the different substances are shown in Fig 4. In cultures of untreated NB4 cells, apoptotic cells are rarely detected (Fig 4A). In contrast, as shown previously,23,24 26 the number of cells showing apoptotic features, such as chromatin condensation and formation of micronuclei, has strongly increased after arsenic treatment (Fig 4B). Similarly, after incubation of the cells with Sb2O3 (Fig4C) and PAT (Fig 4D) the percentage of cells with morpohological signs of apoptosis is significantly augmented. Similar results were obtained in the RA-resistant NB4R4 cells (data not shown). A detailed, quantitative comparison of the apoptotic potential of As2O3 and antimonials in the NB4 and NB4R4 cells is shown in Fig 5. In the absence of any treatment, a low percentage of cells (1% to 3%) show morphological signs of apoptosis. After incubation with As2O3, the percentage of apoptotic cells in cultures of NB4 and NB4R4 cells is about 18% to 20% after 24 hours and 31% to 35% after 48 hours. As can be seen, the apoptotic potential of Sb2O3 and PAT is very similar, although slightly weaker than that of As2O3. After incubation of NB4 or NB4R4 cells for 24 hours with these two compounds, 11% to 14% of the cells can be considered as apoptotic and, 48 hours posttreatment, the percentage of apoptotic cells is increased up to 19% to 25%. In contrast to NB4 cells, U937 cells, a non-APL myeloid leukemia cell line, showed only slightly elevated levels of apoptotic cells following treatment with either As2O3 or antimonials.
Trivalent antimonials induce apoptosis of APL cells. Untreated NB4 cells (A) or cells treated for 24 hours with either 1 μmol/L As2O3 (B), 1 μmol/L Sb2O3 (C), or 1 μmol/L PAT (D) were bound to poly-Lysine treated coverslips, fixed and stained with Hoechst 33258. Apoptotic cells show chromatin condensation and micronuclei.
Trivalent antimonials induce apoptosis of APL cells. Untreated NB4 cells (A) or cells treated for 24 hours with either 1 μmol/L As2O3 (B), 1 μmol/L Sb2O3 (C), or 1 μmol/L PAT (D) were bound to poly-Lysine treated coverslips, fixed and stained with Hoechst 33258. Apoptotic cells show chromatin condensation and micronuclei.
Comparison of the apoptotic potential of As2O3 and antimonials on RA-sensitive and -resistant APL cells and U937 cells. NB4, NB4R4, or U937 cells were incubated for 24 or 48 hours with 1 μmol/L As2O3, 1 μmol/L Sb2O3, or 1 μmol/L PAT, and the percentage of apoptotic cells was determined by Hoechst 33258 staining. Untreated cells were used as control.
Comparison of the apoptotic potential of As2O3 and antimonials on RA-sensitive and -resistant APL cells and U937 cells. NB4, NB4R4, or U937 cells were incubated for 24 or 48 hours with 1 μmol/L As2O3, 1 μmol/L Sb2O3, or 1 μmol/L PAT, and the percentage of apoptotic cells was determined by Hoechst 33258 staining. Untreated cells were used as control.
Taken together these data show that trivalent antimonials at a concentration of 1 μmol/L can efficiently and specifically induce apoptotic cell death in RA-sensitive and RA-resistant APL cells. Comparison with the apoptotic potential of arsenic shows that antimonials are only slightly less effective than arsenic in inducing apoptotic cell death of NB4 and NB4R4 cells.
DISCUSSION
In this report we show that, in vitro, trivalent antimonials have profound effects on APL cells, which are similar to the effects of the antileukemic agents RA and As2O3. The most striking observation is that all three substances can selectively induce degradation of the PML-RARα oncogene and trigger reorganization of the PML NBs. Our results indicate that the mechanisms of both antimony and arsenic action may be identical, as both target specifically the PML moiety of the PML-RARα fusion protein by altering its posttranslational modification profile by SUMO-1. The potential of antimonials to degrade PML-RARα and to reorganize PML NBs is retained in RA-resistant NB4 cells indicating that, as for As2O3, there is no cross-resistance between RA and antimony. As has been reported for As2O3, trivalent antimonials induce apoptotic cell death in RA-sensitive and RA-resistant NB4 cells. Thus, in analogy to As2O3, trivalent antimonials might provide a therapeutic alternative to circumvent RA resistance in APL patients.
A critical feature of the antileukemic activity of both RA and As2O3 seems to be their potential to degrade the PML-RARα oncogene. The most current hypothesis to explain the mechanism of RA-induced degradation is that the conformational change upon ligand binding to the RARα moiety results in the formation of a specific cleavage product. Our recent data28 and the data reported here show that As2O3 and antimony act on the PML moiety of PML-RARα by inducing the attachment of multiple SUMO-1 molecules to PML. Although in the case of the native PML protein, SUMO-1 modification is most likely involved in subcellular partitioning rather than in protein degradation processes, it is possible that in the context of the fusion protein, PML-RARα undergoes a conformational change that allows its recognition by the cellular degradation machinery. The exact molecular mechanism for the induction of poly–SUMO-1 modification of PML by arsenic and antimony is not known. Although the process of SUMO-1 modification resembles ubiquitination, there is increasing evidence that the enzymes implicated in SUMO-1 modification of target proteins are distinct from the enzymes used in classical ubiquitination.41 42 We suggest that As2O3 and antimonials can specifically interact with an enzyme involved in the SUMO-1 modification or demodification process of PML and PML-RARα. The potential to trigger poly–SUMO-1 modification is restricted to trivalent arsenicals and antimonials indicating that binding to vicinal thiol groups is implicated in arsenic/antimony action. Consistent with this hypothesis, pentavalent antimonials and trivalent bismuth salts, which both cannot target vicinal thiols, are not able to induce SUMO-1 attachment to PML. Identification and characterization of the enzymes involved in posttranslational modification by SUMO-1 should help to understand the exact molecular mechanism underlying arsenic/antimony action.
The RA-induced degradation of PML-RARα is paralleled by the restoration of PML NBs, suggesting that NB reorganization may just only be a simple consequence of PML-RARα dissappearance. After arsenic and antimony treatment of NB4 cells, NBs are not only restored but are also dramatically enlarged compared with the normal NBs in non-APL cells. This reorganization may result from two distinct phenomena: (1) the loss of PML-RARα and (2) the poly–SUMO-1 modification of the remaining wild-type PML followed by the recruitment of these poly–SUMO-1–PML conjugates to the NBs.
Initial in vitro studies with As2O3 on APL cells indicate that its therapeutic effect is not related to cell differentiation but is likely due to its ability to provoke apoptotic cell death of APL blasts. In line with this data, we found that trivalent antimonials at micromolar concentrations induce apotosis of RA-sensitive and -resistant APL cells. Recent clinical data from As2O3-treated APL patients showed that, in vivo, As2O3 may have a significant cyto-differentiating effect, as partially differentiated granulocytes are detected in the bone marrow of APL patients after As2O3 treatment.25 Consistent with this observation, it has now been shown that, at subapoptotic concentrations, As2O3 induces a partial differentiation of APL cells in vitro.24 In analogy, we detected an increased expression of myeloid and monocytic cellular differentiation markers (CD11b and CD11c) in a small percentage of cells when NB4 or NB4R4 cells were exposed to sub-apoptotic antimony concentrations (<1 μmol/L) for 3 to 4 days (S.M. and A.D., unpublished results, February 1998). However, as with arsenic, the percentage of cells expressing differentiation markers remains low and terminal differentiation of cells is never achieved with arsenic or antimonials. These data indicate that, like arsenic, antimonials have a dual effect on APL cells, provoking preferentially cell death at relatively high concentration and partial differentiation at lower concentrations. This is in contrast to the effect of RA on APL cells, where a complete terminal differentiation is achieved both in vitro and in vivo. It is not known whether RA and antimony will antagonize each other’s effects when given in combination, as has been reported for RA and arsenic.26
Taken together our data show that the biological effects of trivalent antimonials on NB4 and NB4R4 cells are almost identical to the effects of As2O3. Based on these observations, we propose that trivalent antimonials might also be effective in the treatment of APL patients. This may be of notable clinical relevance, as an effective therapy for RA-resistant APL cases has not yet been established. Recent case reports from China show that As2O3 treatment induces clinical remissions in RA-sensitive and RA-resistant APL patients, and clinical trials in Western countries to evaluate the pharmacology and toxicology of As2O3, as well as its clinical activity, have recently started. In contrast to As2O3, the pharmacological characteristics of trivalent antimonials, especially PAT, are already relatively well studied, as they have been used as antiparasitics in the treatment of Leishmaniosis and Schistosomiasis since the beginning of our century. In the treatment of Leishmaniosis, the trivalent antimony salts have been replaced quite early by the less toxic pentavalent antimonials, but in antischistosomal therapy PAT and other trivalent antimonials were used until the late 1960s. The major side effect observed in antischistosomal therapy with trivalent antimonials was their cardiotoxicity, which, in particular at elevated dose, led to severe complications.43 Based on our in vitro data, we estimate that, for efficient in vivo treatment of APL, serum antimony concentrations in the low micromolar range (∼1 μmol/L) should be sufficient. At that dose PAT is relatively well tolerated, permitting treatment of schistosomiasis patients at moderate toxicity.44 45 Thus, effective treatment of APL patients with antimonials might be accomplished without provoking the side effects known from antischistosomal therapy or from treatment with arsenic.
In conclusion, we have shown that trivalent antimonials have biological effects on APL cells that closely resemble the effects of As2O3. It may thus be estimated that, in analogy to As2O3, trivalent antimonials might have an antileukemic potential in vivo. This could be rapidly tested in the recently described PML-RARα transgenic mice,8-10which provide a useful model for human APL. As trivalent antimonials have widely been used in the past in the treatment of parasitic diseases, their pharmacological characteristics are relatively well studied. It is thus conceivable that antimonials might be included in clinical trials in the near future to compare their therapeutic potential and toxicity to that of arsenic.
ACKNOWLEDGMENT
We are indebted to Marie-Pierre Gaub, Daniel Metzger, Pierre Chambon, Michael J. Matunis, and Günter Blobel for the generous gift of antibodies used in these experiments. We are grateful to Emmanuelle Perret for excellent help with confocal microscopy and Marie-Christine Wagner for kind help with flow cytometry. We thank Pierre Tiollais for support and all members of our group for stimulating discussions and for providing reagents.
Supported by grants from the European Economic Community (EEC), the Association pour la Recherche contre le Cancer, la Fondation pour la Recherche Médicale et le Ministère de la Recherche et de la Technologie. S.M. was supported by a TMR fellowship from the EEC. W.H.M. is a Scholar of the Medical Research Council of Canada.
The publication costs of this article were defrayed in part by page charge payment. This article must therefore be hereby marked “advertisement” in accordance with 18 U.S.C. section 1734 solely to indicate this fact.
REFERENCES
Author notes
Address reprint requests to Anne Dejean, PhD, Unitéde Recombinaison et Expression Génétique, INSERM U 163, Institut Pasteur, 28 rue du Dr Roux, 75724 Paris Cedex 15, France; e-mail: adejean@pasteur.fr.

This feature is available to Subscribers Only
Sign In or Create an Account Close Modal